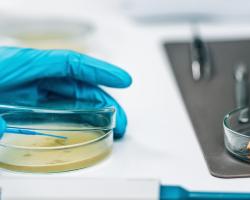
listeria

La biodiversidad urbana acaba de sumar un nuevo y relevante registro con la identificación de la mosca saprófaga Megaselia spiracularis en una vivienda de Santa Coloma de Gramenet (Barcelona). Carlos Pradera y Francisco Javier Maeso documentan el primer hallazgo en España, y en toda Europa, de este fórido con impacto tanto en la salud pública como en la entomología forense.
Miércoles, 08/Abr/2026
Martes, 07/Abr/2026
Jueves, 02/Abr/2026
Artículos destacados
¡Este mes celebramos el primer y productivo año de nuestra App Altimir CheckDot, diseñada para la gestión fácil y eficiente del autocontrol en el sector de la hostelería y las colectividades.! Hoy os hablamos de su módulo para el control de plagas, que permite mantener siempre actualizada y accesible la documentación relacionada: el plan de control, los certificados de visitas, la documentación de los productos utilizados o el calendario de actuaciones.
Notícias
Martes, 31/Mar/2026
Viernes, 27/Mar/2026
Jueves, 26/Mar/2026
Miércoles, 25/Mar/2026
Martes, 24/Mar/2026
Lunes, 23/Mar/2026
Viernes, 20/Mar/2026
- 1
- 2
- …
- siguiente ›
- última »